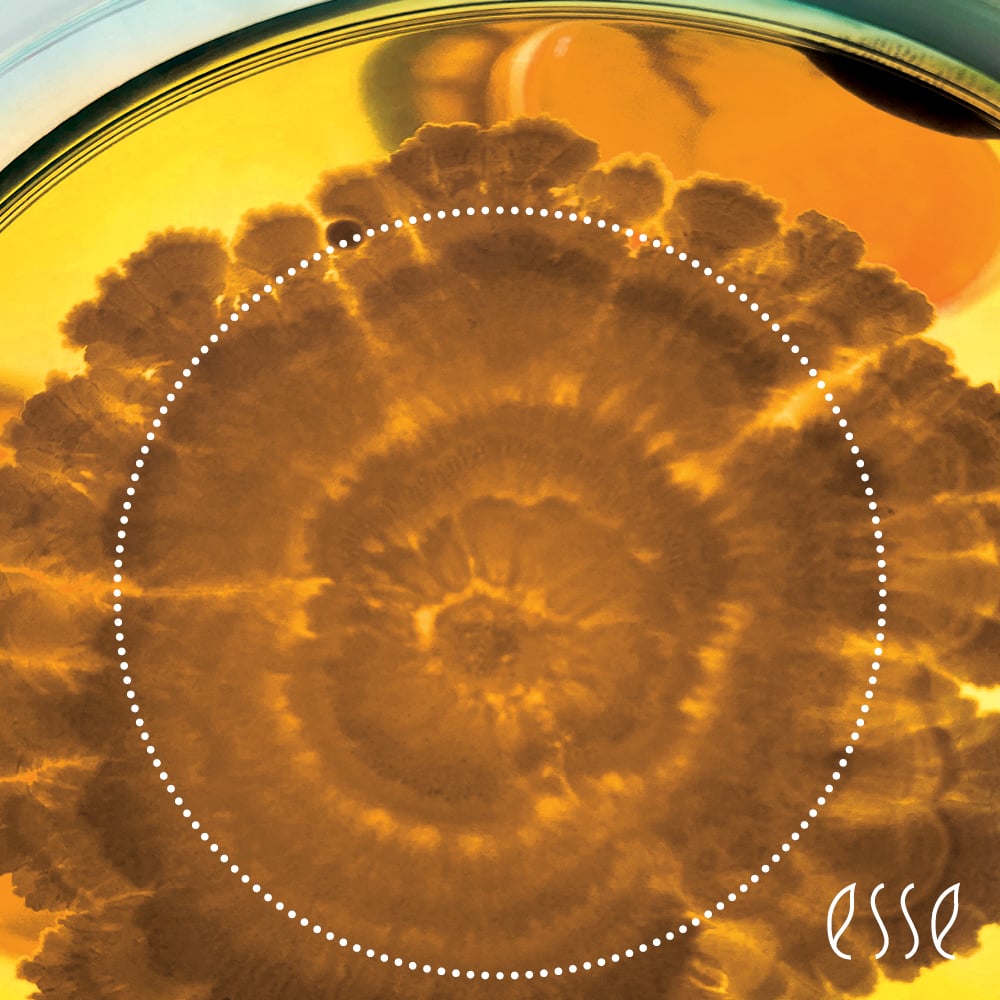
Microbe 2
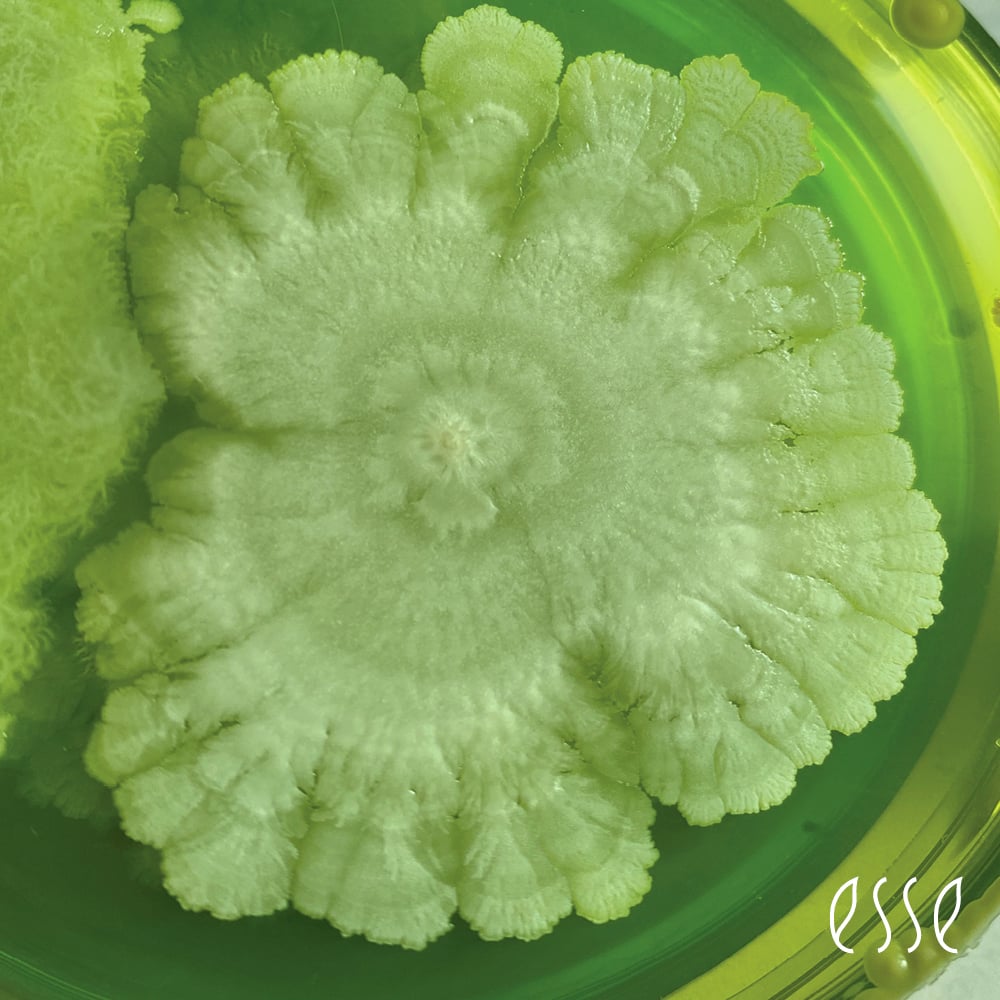
Microbe 3
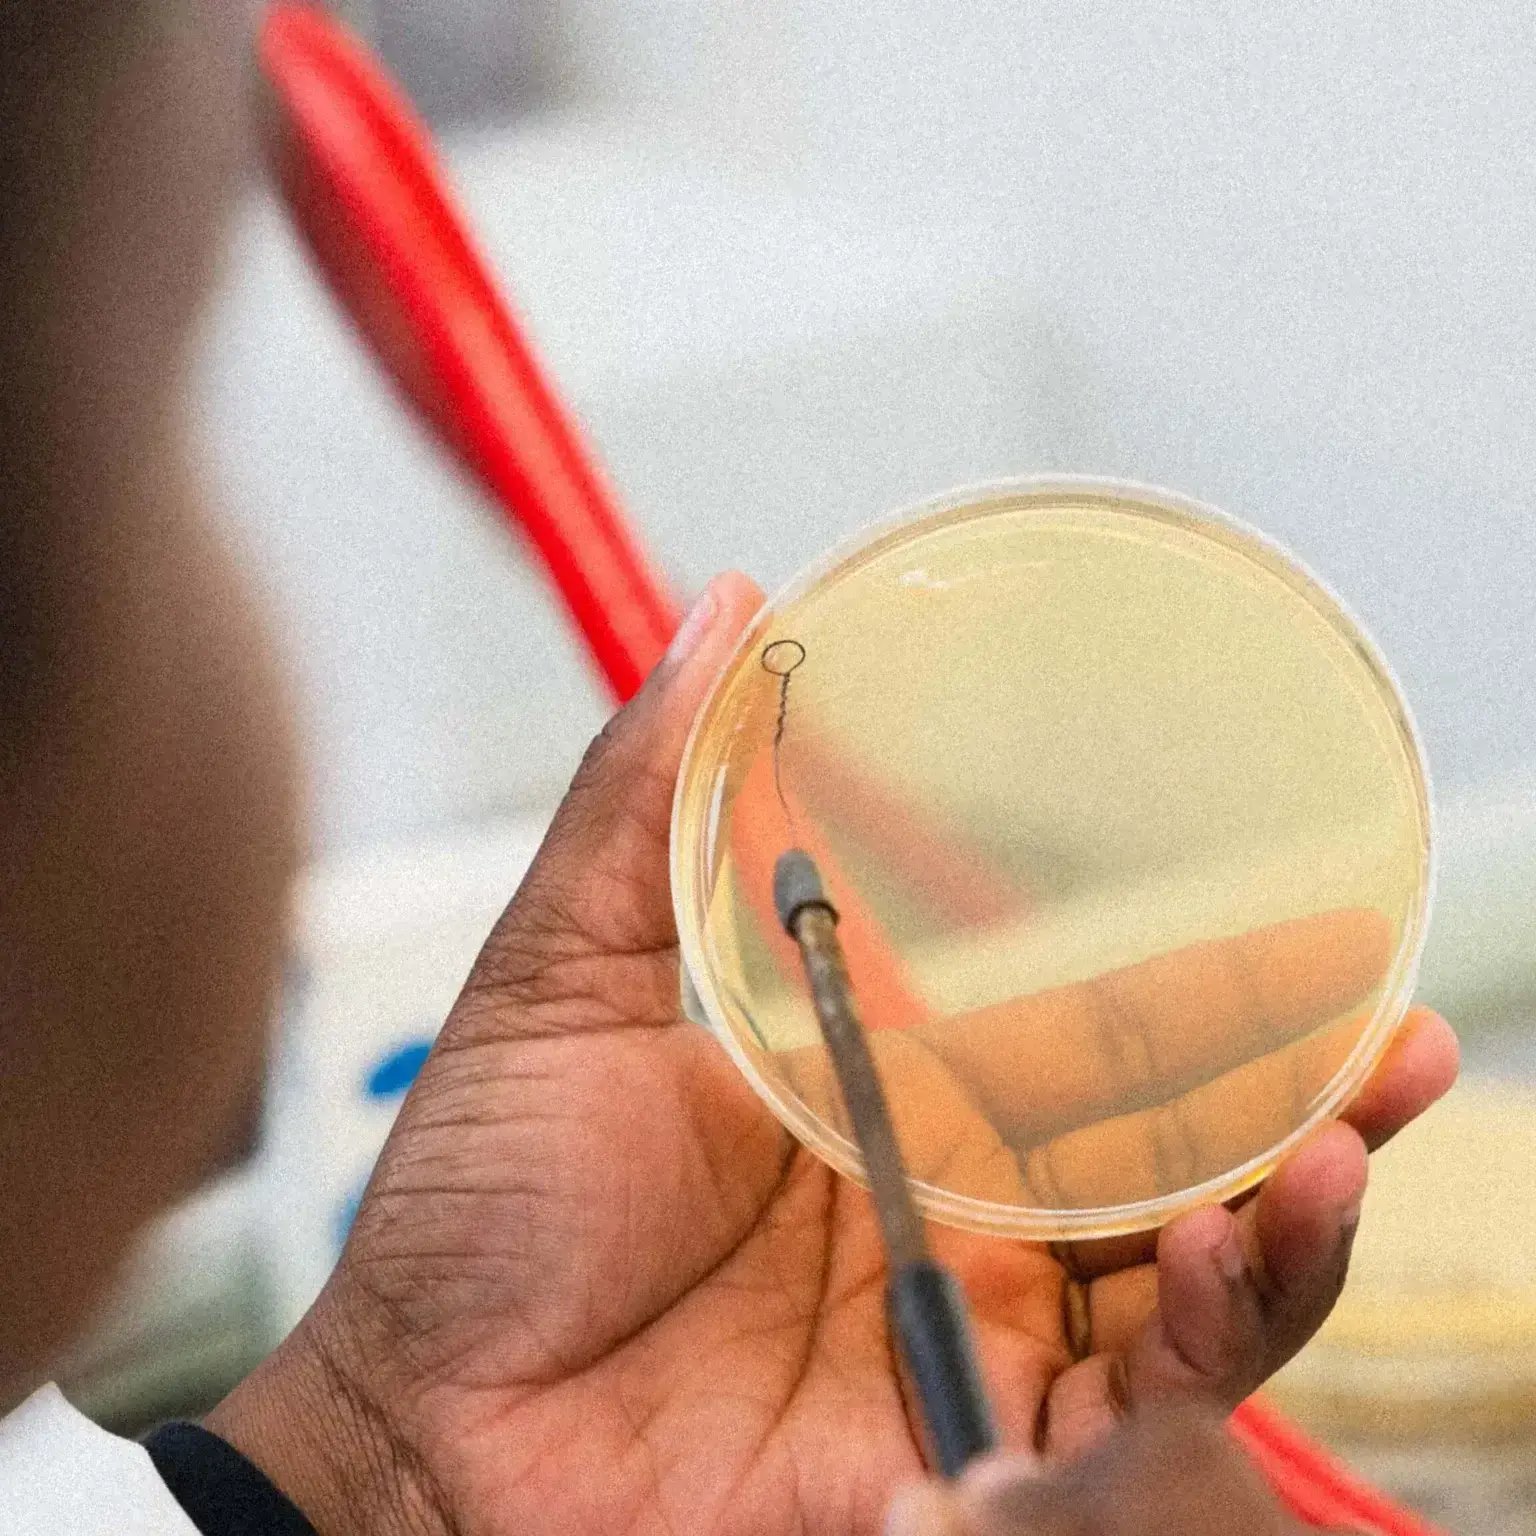
5-Day Microbiome Course

.jpg?width=1080&height=1080&name=Skills%20Ontario%20(Instagram%20Post).jpg)

%20(2)-1.png?width=1080&height=1080&name=Event%20Planner%20Organization%20Promotion%20Instagram%20Post%20(Instagram%20Post)%20(2)-1.png)

Below, you'll find everything you need to successfully tell your clients about the brands and services you offer, with all the benefits, consistently.
You can use these words and images on your social platforms, on signs, and in newsletters - go ahead and download them!
Moor Spa
Moor Spa is a Canadian-made, 100% naturally sourced skin, body, and wellness line for spa professionals. This lifestyle brand offers safe and effective products to transform your clients' skin and overall health.
- Suggested hashtags: #moorspa #moorspapartner #moormud #biodegradable #madeincanada #lmoorbringsmore
- Tag: @moorspanatural and @lmoorbringsmore on Instagram
- Tag: @moorspanatural and @spaneeds on Facebook
Light Elegance
Light Elegance nail enhancements are 9-free, HEMA monomer-free, cruelty-free, gluten-free, and vegan.
Born from Chemistry, Quality, and Community - Light Elegance has developed a vast selection of hypoallergenic, easy-to-apply UV/LED cured colour, glitter, and buttercream gels for elegant nail extensions or overlay, for all skin tones, nail types, and styles.
- Share your beautiful manicures with these suggested hashtags: #LightElegance #ThisisLE #LERocks #LEPPlus #LEGlitterGel #LEColorGel #lmoorbringsmore
- Tag: @lightelegancehq and @lmoorbringsmore on Instagram
- Tag: @LightEleganceHQ and @spaneeds on Facebook
Green Cricket
Green Cricket maintains the balance between personal care products that are healthy and safe for those using them while also being eco-friendly. What does this mean? It means a line of products that you can use anywhere, anytime, for anyone.- Suggested hashtags: #greencricket #greencricketlifestyle #naturalbeautyproducts #madeincanada #lmoorbringsmore
- Tag: @greencricketlifestyle and @lmoorbringsmore on Instagram
- Tag: @greencricketlifestyle and @spaneeds on Facebook
Refectocil
RefectoCil is brow styling made easy, with eyelash and eyebrowtinting and styling products. Help your clients perfect their brow game!
- Suggested hashtags: #refectocil #lmoorbringsmore
- Tag: @refectocilnorthamerica and @lmoorbringsmore on Instagram
- Tag: @refectocilnorthamerica and @spaneeds on Facebook
PREempt
PREempt™ is the only line of disinfectants powered by Accelerated
Hydrogen Peroxide® (AHP®) for the spa and esthetics professional. Responsible: Non-irritating to Eyes and Skin
ECO-FRIENDLY: Breaks down into water and oxygen
Compliant: Helps Get You Inspection Ready
Fast: Kills pathogens in as little as 3 minutes
- Suggested hashtags: #preempt #infectioncontrol #cleanspa #preemptdisinfectants #makingbeautysafe #lmoorbringsmore
- Tag: @preemptdisinfectants and @lmoorbringsmore on Instagram
- Tag: @PREemptDisinfectants and @spaneeds on Facebook

.jpg?width=1080&height=1080&name=Instagram%20Posts%20(1).jpg)









